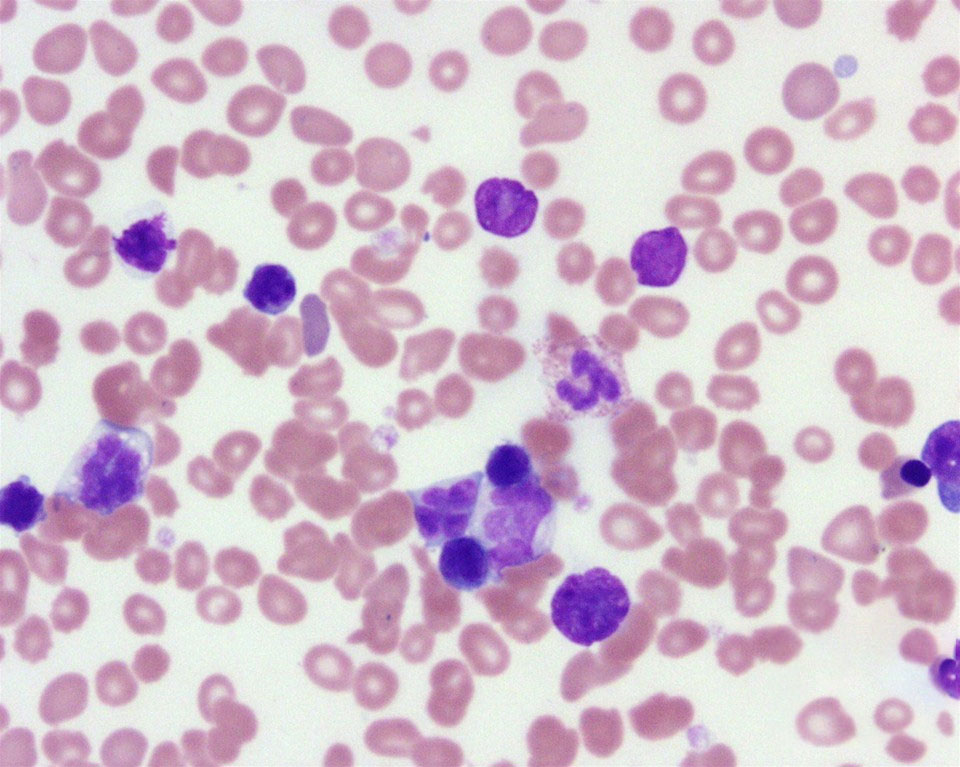
T Cell Lymphoma

Patti Yasutake, renowned for her role as Nurse Alyssa Ogawa in Star Trek Generations, has tragically passed away at the age of 70. Yasutake, who was a beloved figure in the entertainment industry, succumbed to a rare form of T-cell lymphoma after a prolonged battle with the disease. She passed away on Monday, August 5, at UCLA Santa Monica Medical Center. Her longtime manager, Kyle Fritz, shared the news, reflecting on their long history together. Fritz, who began working with Yasutake over 30 years ago, expressed his deep sorrow and appreciation for her spirit, talent, and enduring friendship.
Table of Content:-
A Look Back at Her Career
Patti Yasutake’s career spanned several memorable roles beyond her iconic Star Trek character. She made a notable appearance in Ron Howard’s 1986 comedy Gung Ho and its subsequent ABC spinoff. Her impressive resume includes roles in Drop Dead Gorgeous, Blind Spot, and Road to Galveston. Most recently, Yasutake gained acclaim for her performance in the Netflix limited series Beef, where she played Fumi Nakai. The series won the Best Limited Series award at the 2024 Golden Globes, further cementing Yasutake’s place in Hollywood history.
Understanding T-Cell Lymphoma
As per Dr Mitu Shrikhande, Senior Consultant- Haematology, Fortis Hospital Vasant Kunj, T-cell lymphomas are a rare subset of non-Hodgkin lymphoma, originating from T lymphocytes, a type of white blood cell crucial for immune response. This category of lymphoma is known for its complexity, with various subtypes that affect the body in different ways. T-cell lymphomas can be classified into aggressive and indolent types, each requiring different treatment approaches.
Symptoms of T-Cell Lymphoma
The symptoms of T-cell lymphoma can vary depending on the affected area. Common signs include:
Also Read: Halsey Opens Up On Mental Stress After Miscarriage At 20; Postpartum Depression After a Miscarriage
- Reddish Skin Patches: Typical of cutaneous T-cell lymphoma.
- Heavy Night Sweats: Profuse sweating that soaks bed linens.
- Pain: Discomfort in the abdomen, bones, or chest.
- Persistent Fatigue: Unusual tiredness lasting several days without a clear cause.
- Swollen Lymph Nodes: Painless swelling in areas such as the neck, armpits, or groin.
- Unexplained Fever: A fever that persists above 103°F (39.5°C) despite home treatment.
- Unexplained Weight Loss: Losing 10% of body weight over six months without attempting to do so.
These symptoms may overlap with less severe conditions, but persistent or severe cases warrant consultation with a healthcare provider.
Causes of T-Cell Lymphoma
The precise cause of T-cell lymphoma remains unknown. It generally arises from genetic mutations in T cells that lead to abnormal cell growth. These mutations are acquired rather than inherited and occur during an individual's lifetime.
Treatment Options
Treatment for T-cell lymphoma depends on the specific subtype and can include:
Also Read: Star Wars Actress Daisy Ridley Reveals Her Graves’ Disease Diagnosis; Symptoms To Look Out For
- Chemotherapy: It is the primary treatment for non-Hodgkin lymphomas, including T-cell lymphomas.
- Targeted Therapy: Uses lab-created antibodies to target and destroy specific cancer cells.
- Immunotherapy: Boosts the body’s immune system to fight cancer, including CAR T-cell therapy.
- Radiation Therapy: Employs X-rays or other radiation types to target cancerous cells.
- Chemotherapy with Stem Cell Transplantation: Involves using stem cells to replace damaged bone marrow. This may include autologous or allogeneic stem cell transplantation.
- Clinical Trials: Participation in clinical trials may also be an option, offering access to new treatments and combinations being tested for efficacy.
Bottomline
Patti Yasutake’s passing marks a significant loss to the entertainment world, but her legacy continues through her impactful roles and the public’s remembrance of her contributions. As we reflect on her career and the challenges she faced, awareness of conditions like T-cell lymphoma can inspire further research and support for those affected.
Also watch this video
How we keep this article up to date:
We work with experts and keep a close eye on the latest in health and wellness. Whenever there is a new research or helpful information, we update our articles with accurate and useful advice.
Current Version